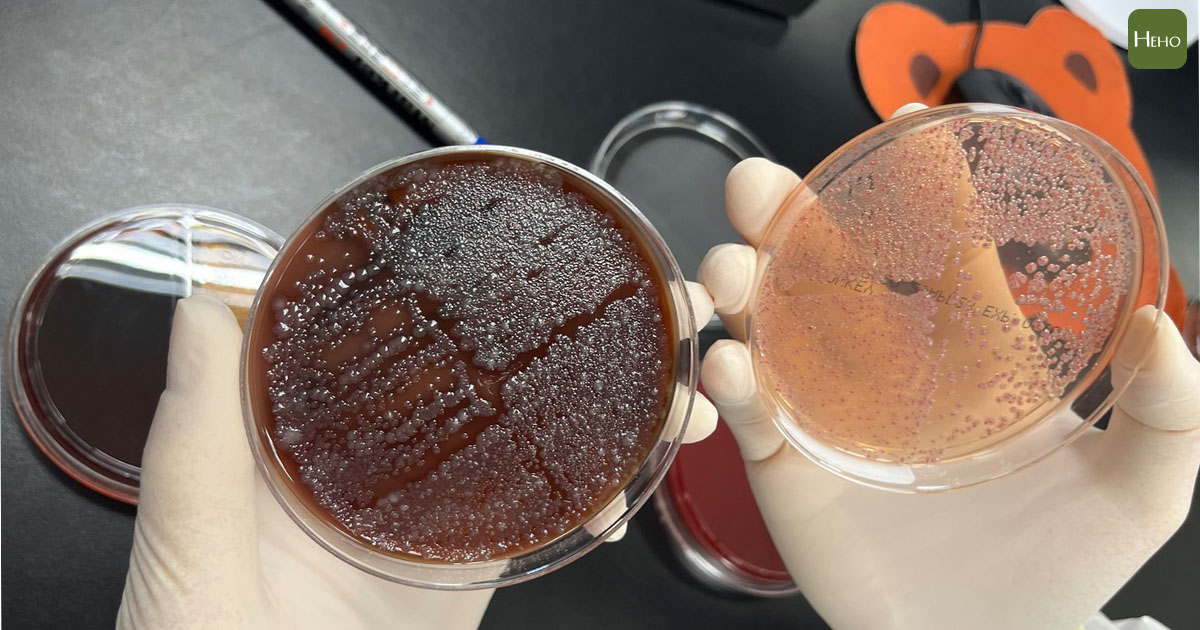

在新冠肺炎疫情之下,也將醫檢人員的重要性推向高峰,需求也可能越來越大!亞東醫院臨床病理科主任朱芳業認為:「未來人口老化之下,民眾檢體量會越來越多,預估五年內成長 20 %。」過往在沒有 AI 輔助之下,需要大量人力的操作各項檢體,如今導入智能數位系統,不僅優化檢驗工序,也替患者提供更好的服務。
醫檢為什麼耗費人力?
到醫院不論是要驗血糖、驗膽固醇、肝功能等等,還是不明的感染症微生物的培養,需要檢驗結果都必須經過檢驗科,但民眾對於此科別好陌生。其實不論是抽血、驗尿、採檢糞便,過往是得經過繁瑣的檢驗流程,才能取得結果,靠的就是醫檢團隊的專業及付出。
醫檢在還沒有 AI 科技幫忙之前,其實是相當耗費人力的工作,亞東醫院醫檢科組長何鎔莉表示:「醫師開單抽血藥檢驗檢驗單,依據不同的檢驗項目有不同的試管,需要人工去對試管、貼條碼,再利用升降梯運送檢體到對應儀器,把檢體進行離心。」

朱芳業舉例:「去年疫情嚴重時候檢驗突然衝起來,原本平均檢體是 250 ,一下增加到 330,傳統醫檢人員需要花非常多的時間處理培養皿,需要來回反覆人工畫線,長時間重複性的動作也會造成醫檢師手部肌肉嚴重僵硬。」但如今這些流程都可以自動化完成。
自動化、影像管理AI輔助判讀!讓醫檢人力提高效能
原本血液培養得經由 66 個步驟,如今可以精簡為 19 個步驟,不論在接種、培養、影像判讀、都可以靠細菌譜質儀器處理來完成,將人力運用在更重要的地方。
臨床病理科也是醫師,並非直接面對到患者,但他替患者的檢驗內容把關,診斷的醫師也會時常跟臨床病理科醫師進行討論,在優化檢驗流程後,節省下的人力時間, 就可運用在有效力的地方,朱芳業說:「很多細菌其實跟人一樣,沒有一隻是長一樣的,所以過去你只能說照常規這麼做,在節省人力下你可以做花更多時間跟臨床醫師做這溝通。」
因此,亞東醫院近年來推展智慧醫療,其中病床病理科也是重點發展的科別,AI 智能化醫事服務,且不單只是減少人力成本,藉由標準化流程與智慧溫箱影像監控,細菌培養的結果可以藉由遠端的方式,迅速知道病人感染狀況。

朱芳業說:「像是腦脊椎病人狀況不好時間急迫,每看一次就要在 1000 片培養皿中裡面找那一片出來,但現在有自動化的影像監測,讓醫師迅速了解病人感染狀況。提高報告的時效,讓醫師更迅速掌握結果,讓醫師更快速處理病人感染情況。」
另外, 朱芳業也透露臨床病理科面臨的困境,「現在少子化下徵聘人非常不容易,今年全國的醫檢師考高率報考率不到10%,除了招生人變少、考試及格的人變少,未來臺灣會需要這些高度的技術的人材。」
在走向精準醫療的時代下,整合性的檢驗服務也是下個著重的重點,AI 輔助下才可以讓醫檢團隊發揮更大的醫檢效能,讓患者帶來更好的醫療品質。

諮詢醫師:亞東醫院臨床病理科主任朱芳業
文、王芊淩/圖、巫郡俊
延伸閱讀:
新檢測讓病原檢出率提升 60%!構建醫療防護網防堵未知感染疾病
別再遺忘守住新冠的「隱形超人」!全台醫檢師讓檢驗量5個月翻12倍
我是廣告 請繼續往下閱讀
到醫院不論是要驗血糖、驗膽固醇、肝功能等等,還是不明的感染症微生物的培養,需要檢驗結果都必須經過檢驗科,但民眾對於此科別好陌生。其實不論是抽血、驗尿、採檢糞便,過往是得經過繁瑣的檢驗流程,才能取得結果,靠的就是醫檢團隊的專業及付出。
醫檢在還沒有 AI 科技幫忙之前,其實是相當耗費人力的工作,亞東醫院醫檢科組長何鎔莉表示:「醫師開單抽血藥檢驗檢驗單,依據不同的檢驗項目有不同的試管,需要人工去對試管、貼條碼,再利用升降梯運送檢體到對應儀器,把檢體進行離心。」

朱芳業舉例:「去年疫情嚴重時候檢驗突然衝起來,原本平均檢體是 250 ,一下增加到 330,傳統醫檢人員需要花非常多的時間處理培養皿,需要來回反覆人工畫線,長時間重複性的動作也會造成醫檢師手部肌肉嚴重僵硬。」但如今這些流程都可以自動化完成。
自動化、影像管理AI輔助判讀!讓醫檢人力提高效能
原本血液培養得經由 66 個步驟,如今可以精簡為 19 個步驟,不論在接種、培養、影像判讀、都可以靠細菌譜質儀器處理來完成,將人力運用在更重要的地方。
臨床病理科也是醫師,並非直接面對到患者,但他替患者的檢驗內容把關,診斷的醫師也會時常跟臨床病理科醫師進行討論,在優化檢驗流程後,節省下的人力時間, 就可運用在有效力的地方,朱芳業說:「很多細菌其實跟人一樣,沒有一隻是長一樣的,所以過去你只能說照常規這麼做,在節省人力下你可以做花更多時間跟臨床醫師做這溝通。」
因此,亞東醫院近年來推展智慧醫療,其中病床病理科也是重點發展的科別,AI 智能化醫事服務,且不單只是減少人力成本,藉由標準化流程與智慧溫箱影像監控,細菌培養的結果可以藉由遠端的方式,迅速知道病人感染狀況。
另外, 朱芳業也透露臨床病理科面臨的困境,「現在少子化下徵聘人非常不容易,今年全國的醫檢師考高率報考率不到10%,除了招生人變少、考試及格的人變少,未來臺灣會需要這些高度的技術的人材。」
在走向精準醫療的時代下,整合性的檢驗服務也是下個著重的重點,AI 輔助下才可以讓醫檢團隊發揮更大的醫檢效能,讓患者帶來更好的醫療品質。

文、王芊淩/圖、巫郡俊
延伸閱讀:
新檢測讓病原檢出率提升 60%!構建醫療防護網防堵未知感染疾病
別再遺忘守住新冠的「隱形超人」!全台醫檢師讓檢驗量5個月翻12倍